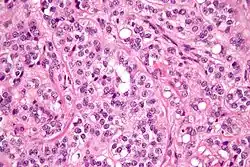

Sertoli cell tumour
| Sertoli cell tumour | |
|---|---|
| |
| Micrograph of a Sertoli cell tumour. H&E stain. | |
| Specialty | Oncology |
A Sertoli cell tumour, also Sertoli cell tumor (US spelling), is a sex cord–gonadal stromal tumour of Sertoli cells. They can occur in the testis or ovary. They are very rare and generally peak between the ages of 35 and 50. They are typically well-differentiated and may be misdiagnosed as seminomas as they often appear very similar.[1]
A tumor that produces both Sertoli cells and Leydig cells is known as a Sertoli–Leydig cell tumor.
Presentation
In males, Sertoli cell tumours typically present as a testicular mass or firmness, and their presence may be accompanied by gynaecomastia (25%) if they produce oestrogens, or precocious pseudopuberty in young boys, especially if they produce androgens.[2]
Diagnosis

On ultrasound, a Sertoli cell tumour appears as a hypoechoic intratesticular lesion which is usually solitary. However, the large cell subtype might present as multiple and bilateral masses with large areas of calcification. An MRI may also be conducted, but this typically is not definitive.[2]
Microscopy and immunohistochemistry are the only way to give a definitive diagnosis, especially when there is a suspected seminoma.[3]
Treatment
In males, due to the difficulty in identifying the tumour using imaging techniques, an orchiectomy is often performed. The majority of Sertoli cell tumours are benign, so this is sufficient. There is no documented benefit of chemotherapy or radiotherapy.[4]
In non-humans
Sertoli cell tumors are known to occur in other species, including domestic ducks,[5] dogs,[6][7] and horses.
Additional images
-
 Micrograph of a Leydig cell tumour
Micrograph of a Leydig cell tumour -
 Micrograph of a Leydig cell tumour
Micrograph of a Leydig cell tumour
See also
Notes
- ^ Young, Robert H. (2005-01-01). "Sex cord-stromal tumors of the ovary and testis: their similarities and differences with consideration of selected problems". Modern Pathology. 18 (S2): S81 – S98. doi:10.1038/modpathol.3800311. ISSN 0893-3952. PMID 15502809.
- ^ a b Morgan, Matt A. "Sertoli cell tumour of the testis | Radiology Reference Article | Radiopaedia.org". radiopaedia.org. Retrieved 2016-12-06.
- ^ Henley, John D.; Young, Robert H.; Ulbright, Thomas M. (2002-05-01). "Malignant Sertoli cell tumors of the testis: a study of 13 examples of a neoplasm frequently misinterpreted as seminoma". The American Journal of Surgical Pathology. 26 (5): 541–550. doi:10.1097/00000478-200205000-00001. ISSN 0147-5185. PMID 11979085. S2CID 33939867.
- ^ "Testis and epididymis - Sertoli cell tumor, NOS". www.pathologyoutlines.com. Retrieved 2016-12-06.
- ^ Leach S, Heatley JJ, Pool RR, Spaulding K (December 2008). "Bilateral testicular germ cell-sex cord-stromal tumor in a pekin duck (Anas platyrhynchos domesticus)". J. Avian Med. Surg. 22 (4): 315–9. doi:10.1647/2007-017.1. PMID 19216259. S2CID 24196361.
- ^ Gopinath D, Draffan D, Philbey AW, Bell R (December 2008). "Use of intralesional oestradiol concentration to identify a functional pulmonary metastasis of canine sertoli cell tumour". J Small Anim Pract. 50 (4): 198–200. doi:10.1111/j.1748-5827.2008.00671.x. PMID 19037884.
- ^ Vegter AR, Kooistra HS, van Sluijs FJ, van Bruggen LW, Ijzer J, Zijlstra C, Okkens AC (October 2008). "Persistent Mullerian Duct Syndrome in a Miniature Schnauzer Dog with Signs of Feminization and a Sertoli Cell Tumour". Reprod. Domest. Anim. 45 (3): 447–52. doi:10.1111/j.1439-0531.2008.01223.x. PMID 18954385.
External links
 Media related to Sertoli cell tumor at Wikimedia Commons
Media related to Sertoli cell tumor at Wikimedia Commons